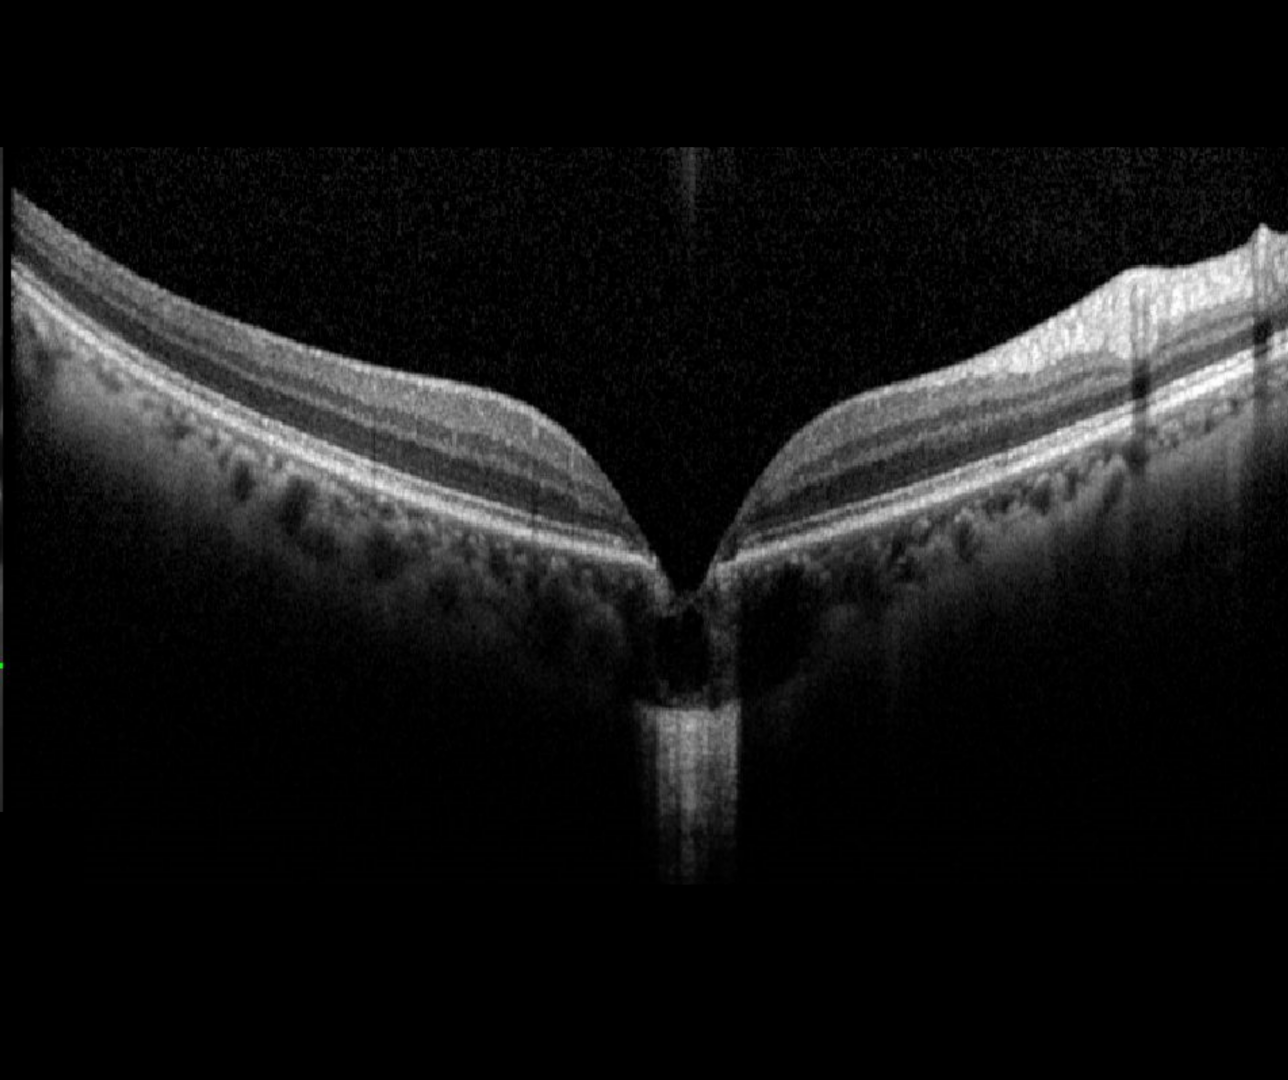

Overview
Intra-choroidal cavitation at the macula has been described as a focal loss of the outer retina and RPE, with the remaining inner retina making direct contact with the sclera resulting in a “pseudo-fovea” appearance.
These lesions are associated with high myopia and often found on or around patchy chorioretinal atrophy.
They are distinguished from focal choroidal excavation by the involvement of both the choroid and sclera with the sclera found to be posteriorly bowed in approximately half of all cases. FCE in contrast affects only the choroid and the scleral remains unaffected.
Peripapillary intrachoroidal cavitation (PICC) presents on OCT as intrachoroidal hyporeflective spaces with normal retina and RPE overlying it. Half of all cases show an orange-yellow lesion on fundus photography.
The Beijing eye study (2013) found PICC were typically associated with highly tilted optic discs and the presence of a posterior staphyloma.
They may cause glaucoma-like visual field defects.
Case Examples
-
Case 1: Macular intrachoroidal cavitation
A 56 year old Asian female with high myoipa (-6.00DS) and best corrected visual acuity of 6/7.5 in the right eye.
-
Case 2: Peripapillary intrachoroidal cavitation
A 54 year old Asian female with high myopia (-6.25/-0.75 x 180) in the right eye and moderate myopia (-4.00DS) in the left eye. her best corrected visual acuity is 6/6 (20/20) in each eye.
This patient has been followed at CFEH for 6 years with no progression of either the structural or functional defects seen in the imaging. In this case, the peripapillary intrachoroidal cavitation is believed to be causing a glaucomatous-like field defect.
Fundus photo and red free image (right eye)
More infoFundus photo and red free image (left eye)
More infoStereoscopic image (right optic disc)
More infoStereoscopic image (left optic disc)
More infoSpectralis OCT line scans (right optic disc)
More infoSpectralis OCT radial line scan (right optic disc)
More infoSpectralis OCT line scans (left optic disc)
More infoCirrus RNFL analysis
More infoCirrus ganglion cell analysis
More info24-2 SITA standard
More info
Differential Diagnosis
References
Chen, Y., Ma, X. & Hua, R. (2018) Multi-modality imaging findings of huge intrachoroidal cavitation and myopic peripapillary sinkhole. BMC Ophthalmol 18, 24 (2018).
Ohno-Matsui K, Akiba M, Moriyama M, Ishibashi T, Hirakata A, Tokoro T. (2012) Intrachoroidal cavitation in macular area of eyes with pathologic myopia. Am J Ophthalmol. Aug;154(2):382-93.
Ohno-Matsui, K., Shimada, N., Akiba, M., Moriyama, M., Ishibashi, T., & Tokoro, T. (2013). Characteristics of intrachoroidal cavitation located temporal to optic disc in highly myopic eyes. Eye (London, England), 27(5), 630–638.
You QS, Peng XY, Chen CX, Xu L, Jonas JB (2013) Peripapillary Intrachoroidal Cavitations. The Beijing Eye Study. PLOS ONE 8(10): e78743.